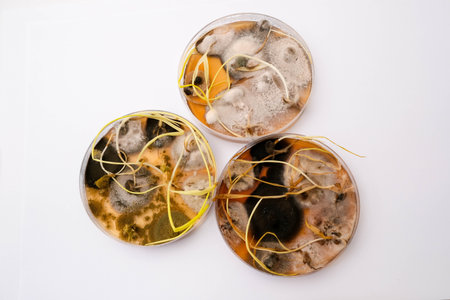
photo of fungi growth on agar media in petri dishの写真素材

写真素材 - photo of fungi growth on agar media in petri dish
キーワード
- abstract
- agar
- bacteria
- biology
- black
- blue
- closeup
- colonies
- crop
- culture
- danger
- dish
- ecoli
- fungi
- fungus
- grain
- growth
- health
- infection
- inflection
- isolated
- lab
- laboratory
- medical
- medicine
- microbiology
- mildew
- mold
- natural
- old
- petrie
- piece
- plate
- poisonous
- research
- rotten
- seed
- seeds
- species
- spores
- spread
- test
- toxic
類似作品
Mushroom cultiv...
Close up petri ...
Backgrounds of ...
Penicillium, as...
Fungal Growth a...
Mushroom cultiv...
mold in orange ...
A detailed view...
Backgrounds of ...
Fungi colonies ...
bone marrow sam...
close-up of col...
The mesmerizing...
Microscopic vie...
Various types o...
close-up of bac...
Microscopic vie...
Colony characte...
close-up, micro...
In the microsco...
Futuristic Petr...
Backgrounds of ...
Penicillium, as...
Close-up of a s...
The mesmerizing...
Colony characte...
Mixed of bacter...
Backgrounds of ...
Backgrounds of ...
Explore the uns...
Diverse microor...
Bacterial growt...
Backgrounds of ...
Colony characte...
Fungi culture o...
on agar in a pe...
Laboratory tabl...
Backgrounds of ...
closeup shot of...
A gloved hand r...
agar plates wit...
Colony characte...
Macro. top view...
mold on eggplan...
Backgrounds of ...
Abstract ink te...
Colony characte...
A detailed view...
Colorful variet...